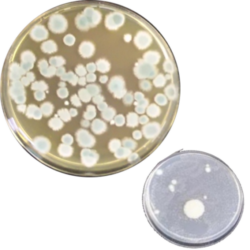

ハニカムの構造について、前回はお話しました。
ハニカムが汚れている現状もお伝えしてきました。
では、ハニカムの汚れは、どのぐらいなのでしょうか?

大阪産業技術研究所の分析によると、ハニカムに付着した汚れから、大量のカビやバクテリアが検出されました。そのレベルは、トイレの便器以上のレベルという結果でした。

020430号
受け入れがたい事実ではありますが、この中を通った空気が食品に送り込まれているのが現状です。
知ってしまうと、普段のスーパーでの買い物も、ためらってしまいますよね・・・。

ハニカムの汚れ対策には、ハニカム抗菌シートⓇを。
ハニカムに設置するだけでホコリや汚れをキャッチ。
定期的なシート交換のみで、ハニカムを清潔に保ちます。
特許登録:第7216416号 商標登録:第6635033号

Comments are closed